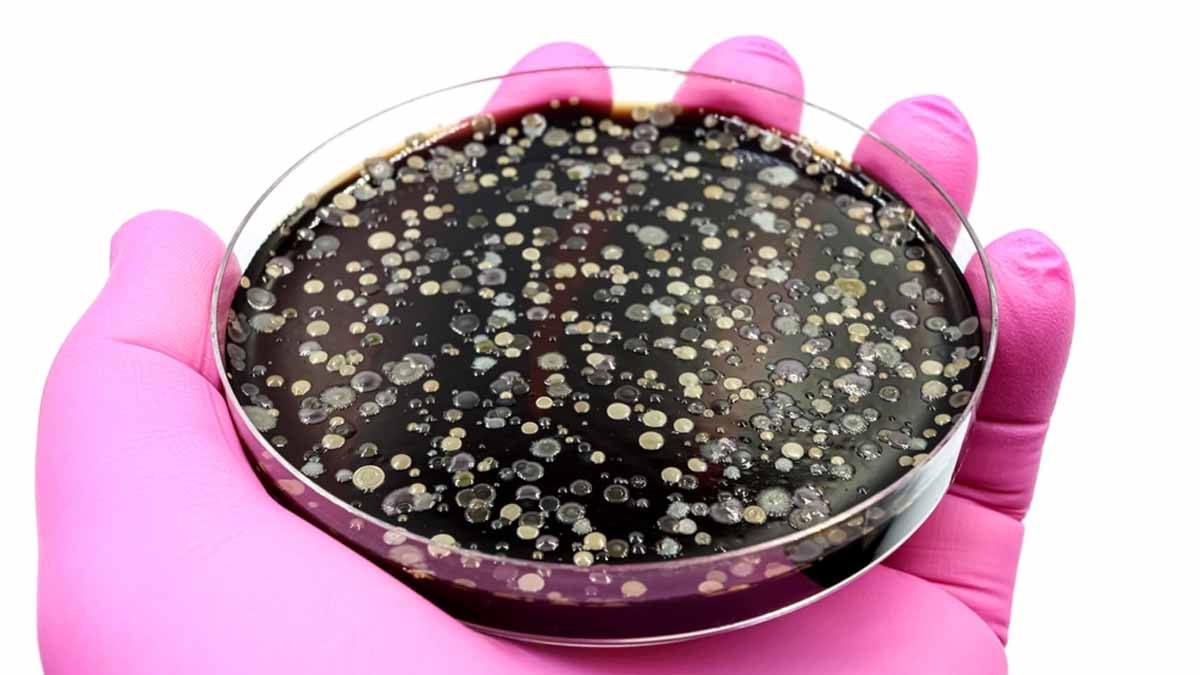

Ayrana maden suyu eklemenin meğer böyle bir faydası varmış
Yazın sıklıkla tercih ettiğimiz içeceklerden biri olan maden suyu ve ayranı birlikte içince vücuda olan faydası ikiye katlanıyormuş. İşte bu karışımın şaşırtan faydaları...
Ayrana maden suyu eklemenin meğer böyle bir faydası varmış
Yazın sıklıkla tercih ettiğimiz içeceklerden biri olan maden suyu ve ayranı birlikte içince vücuda olan faydası ikiye katlanıyormuş. İşte bu karışımın şaşırtan faydaları...
 Odaya bir tane koymanız yetiyor: Rutubeti hemen yok ediyor
Evinizde rutubet problemi yaşıyorsanız, bu doğal yöntem ilginizi çekebilir. Nem kaynaklı küf ve mantar oluşumu, zamanla yalnızca duvarlarınıza zarar vermekle kalmaz, sağlığınız için de risk oluşturur. Ancak, bu bitki ile sorunu doğal yolla ortadan kaldırmak mümkün.
Odaya bir tane koymanız yetiyor: Rutubeti hemen yok ediyor
Evinizde rutubet problemi yaşıyorsanız, bu doğal yöntem ilginizi çekebilir. Nem kaynaklı küf ve mantar oluşumu, zamanla yalnızca duvarlarınıza zarar vermekle kalmaz, sağlığınız için de risk oluşturur. Ancak, bu bitki ile sorunu doğal yolla ortadan kaldırmak mümkün.
 Osmanlı’da Türk demek yasak mıydı?
Cumhuriyet’in en güçlü kalemlerinden Falih Rıfkı Atay’ın anılarında, ‘Türk’ kelimesinin nasıl kaba
ve yabani sayıldığını, ‘vatan’ sözünün neden yasaklandığını ve bir milletin kimliğini nasıl yeniden
inşa ettiğini keşfedeceğiz.
Osmanlı’da Türk demek yasak mıydı?
Cumhuriyet’in en güçlü kalemlerinden Falih Rıfkı Atay’ın anılarında, ‘Türk’ kelimesinin nasıl kaba
ve yabani sayıldığını, ‘vatan’ sözünün neden yasaklandığını ve bir milletin kimliğini nasıl yeniden
inşa ettiğini keşfedeceğiz.
 Brezilya'da Afra Saraçoğlu dersi!
Afra Saraçoğlu'nun 'Kardeş Çocukları' dizisindeki kömürlük sahnesi Brezilya'daki üniversitede ders olarak okutuluyor.
Brezilya'da Afra Saraçoğlu dersi!
Afra Saraçoğlu'nun 'Kardeş Çocukları' dizisindeki kömürlük sahnesi Brezilya'daki üniversitede ders olarak okutuluyor.
 ATM'ler bu yüzden kart yutuyormuş
Günümüzde sıkça kullandığımız ATM’leri doğru şekilde kullanmak büyük önem taşıyor. İddialara göre, ATM’lerin kart yutma olayı çoğu zaman teknik bir arızadan değil, güvenlik amacıyla uygulanan bir yöntemden kaynaklanıyor. İşte bu durumun nedenleri ve yapılması gerekenler…
ATM'ler bu yüzden kart yutuyormuş
Günümüzde sıkça kullandığımız ATM’leri doğru şekilde kullanmak büyük önem taşıyor. İddialara göre, ATM’lerin kart yutma olayı çoğu zaman teknik bir arızadan değil, güvenlik amacıyla uygulanan bir yöntemden kaynaklanıyor. İşte bu durumun nedenleri ve yapılması gerekenler…
 60 yıllık marka marketlerde domuz eti satmış: Yine yakalandılar
60 yıl boyunca “güven” sloganıyla sofralara giren marka, yine aynı skandalla gündemde. Dana sucuk diye satılan üründen domuz eti çıktı. Tarım ve Orman Bakanlığı’nın denetimleri, gıda sektöründe yılların tecrübesine sahip firmaların bile tüketiciyi nasıl aldattığını bir kez daha gözler önüne serdi.
60 yıllık marka marketlerde domuz eti satmış: Yine yakalandılar
60 yıl boyunca “güven” sloganıyla sofralara giren marka, yine aynı skandalla gündemde. Dana sucuk diye satılan üründen domuz eti çıktı. Tarım ve Orman Bakanlığı’nın denetimleri, gıda sektöründe yılların tecrübesine sahip firmaların bile tüketiciyi nasıl aldattığını bir kez daha gözler önüne serdi.
 Anketlerin dili AKP'ye kötü haber getirdi!
AKP'ye kötü haber geldi. Türkiye'deki her 5 kişiden 3’ü CHP’li belediyelere yönelik operasyonların yolsuzlukla mücadeleden çok; siyasi gerekçelerle yapıldığını düşünüyor. KONDA Araştırma'nın son çalışması kamuoyundaki algıyı ortaya koydu.
Anketlerin dili AKP'ye kötü haber getirdi!
AKP'ye kötü haber geldi. Türkiye'deki her 5 kişiden 3’ü CHP’li belediyelere yönelik operasyonların yolsuzlukla mücadeleden çok; siyasi gerekçelerle yapıldığını düşünüyor. KONDA Araştırma'nın son çalışması kamuoyundaki algıyı ortaya koydu.
 8 yıl sonra yasak sona erdi: Konutta yeni stüdyo daire dönemi
2017 yılında yapımı yasaklanan 1+0 daireler, Resmi Gazete’de yayımlanan kararla yeniden inşa edilebilecek. Yapılacak yeni stüdyo daireler, belirlenen yeni standartlar ve bazı teknik koşullara bağlı olacak.
8 yıl sonra yasak sona erdi: Konutta yeni stüdyo daire dönemi
2017 yılında yapımı yasaklanan 1+0 daireler, Resmi Gazete’de yayımlanan kararla yeniden inşa edilebilecek. Yapılacak yeni stüdyo daireler, belirlenen yeni standartlar ve bazı teknik koşullara bağlı olacak.
50 milyar bakteriyle evin en kirli 2. yeri seçildi, üstelik hiçbir temizleme yöntemi de yüzde 100 dezenfekte etmiyor
Nature dergisinde yayınlanan çalışma, basit bir eşyanın tuvaletten bile daha fazla mikrop barındırdığını kanıtladı. En kötü haber ise, onu ne kadar temizlerseniz temizleyin asla tam olarak dezenfekte olmuyor.
50 milyar bakteriyle evin en kirli 2. yeri seçildi, üstelik hiçbir temizleme yöntemi de yüzde 100 dezenfekte etmiyor
Nature dergisinde yayınlanan çalışma, basit bir eşyanın tuvaletten bile daha fazla mikrop barındırdığını kanıtladı. En kötü haber ise, onu ne kadar temizlerseniz temizleyin asla tam olarak dezenfekte olmuyor.
 Hakkı Bulut'un Ferdi Tayfur iddialarına günler sonra yanıt: Mevzu tamamen asılsız
2 Ocak'ta vefat eden Ferdi Tayfur hakkında açıklama yapan Hakkı Bulut'a yalanlama geldi.
Hakkı Bulut'un Ferdi Tayfur iddialarına günler sonra yanıt: Mevzu tamamen asılsız
2 Ocak'ta vefat eden Ferdi Tayfur hakkında açıklama yapan Hakkı Bulut'a yalanlama geldi.
 Kamyondan fırlayan taş çocuğu öldürdü
Balıkesir’in Burhaniye ilçesinde, belediyeye ait hafriyat kamyonunun tekerinden fırlayan taş, karşı yönden gelen otomobilin ön camını kırarak 3,5 yaşındaki Teoman Konya’nın ölümüne neden oldu.
Kamyondan fırlayan taş çocuğu öldürdü
Balıkesir’in Burhaniye ilçesinde, belediyeye ait hafriyat kamyonunun tekerinden fırlayan taş, karşı yönden gelen otomobilin ön camını kırarak 3,5 yaşındaki Teoman Konya’nın ölümüne neden oldu.
 Kendi ölümünü dahi bilmişti: İşte Nostradamus'un tüyler ürperten 2026 kehanetleri
16. yüzyılın ünlü kahini Nostradamus’un 2026 yılı için yaptığı öngörüler, savaş, iklim felaketleri, ekonomik çöküş ve küresel düzenin değişeceği iddialarıyla dikkat çekiyor. Kehanetlerde III. Dünya Savaşı’ndan, devasa iklim krizlerine, gıda kıtlığından teknolojinin insanlığı ele geçirmesine kadar pek çok çarpıcı senaryo yer alıyor.
Kendi ölümünü dahi bilmişti: İşte Nostradamus'un tüyler ürperten 2026 kehanetleri
16. yüzyılın ünlü kahini Nostradamus’un 2026 yılı için yaptığı öngörüler, savaş, iklim felaketleri, ekonomik çöküş ve küresel düzenin değişeceği iddialarıyla dikkat çekiyor. Kehanetlerde III. Dünya Savaşı’ndan, devasa iklim krizlerine, gıda kıtlığından teknolojinin insanlığı ele geçirmesine kadar pek çok çarpıcı senaryo yer alıyor.